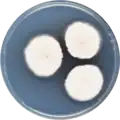
Aspergillus spinulosporus growing on CYA plate

Aspergillus spinulosporus
| Aspergillus spinulosporus | |
|---|---|
| Scientific classification | |
| Kingdom: | Fungi |
| Division: | Ascomycota |
| Class: | Eurotiomycetes |
| Order: | Eurotiales |
| Family: | Aspergillaceae |
| Genus: | Aspergillus |
| Species: | A. spinulosporus
|
| Binomial name | |
| Aspergillus spinulosporus Hubka, S.W. Peterson, M. Kolařík (2016)[1]
| |
| Synonyms | |
|
A. delacroxcii and A. neoechinulatus | |
Aspergillus spinulosporus is a species of fungus in the genus Aspergillus. It is from the Nidulantes section.[2] It was first described in 2016.[1] It has been reported to produce asperthecin, echinocandin B1, desferritriacetylfusigen, and sterigmatocystin.[2]
In 2016, the genome of A. spinulosporus was, under the name A. neoechinulatus, sequenced as a part of the Aspergillus whole-genome sequencing project - a project dedicated to performing whole-genome sequencing of all members of the genus Aspergillus.[3] The genome assembly size was 30.67 Mbp.[3]
Growth and morphology
A. spinulosporus has been cultivated on both Czapek yeast extract agar (CYA) plates and Malt Extract Agar Oxoid® (MEAOX) plates. The growth morphology of the colonies can be seen in the pictures below.
-
Aspergillus spinulosporus growing on CYA plate
Aspergillus spinulosporus growing on CYA plate -
 Aspergillus spinulosporus growing on MEAOX plate
Aspergillus spinulosporus growing on MEAOX plate
References
- ^ a b Hubka, V; Nováková, A; Peterson, S.W; Frisvad, J.C; Sklenář, F; Matsuzawa, T; Kubátová, A; Kolařík, M. 2016. A reappraisal of Aspergillus section Nidulantes with descriptions of two new sterigmatocystin producing species. Plant Systematics and Evolution. 302(9):1267-1299
- ^ a b Chen, A.J.; Frisvad, J.C.; Sun, B.D.; Varga, S.; Kocsubé, S.; Dijksterhuis, J.; Kim, D.H.; Hong, S.-B.; Houbraken, J.; Samson, R.A. (2016). "Aspergillus section Nidulantes (formerly Emericella): Polyphasic taxonomy, chemistry and biology". Studies in Mycology. 84: 1–118. doi:10.1016/j.simyco.2016.10.001. PMC 5198626. PMID 28050053.
- ^ a b "Home - Aspergillus neoechinulatus CBS120.55 v1.0". genome.jgi.doe.gov.